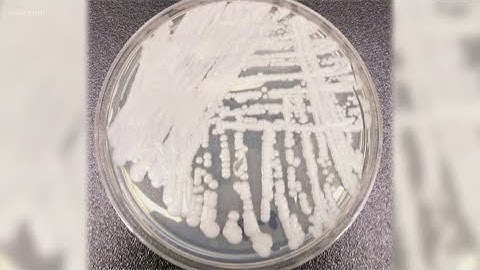
CDC warns about drug-resistant superbug
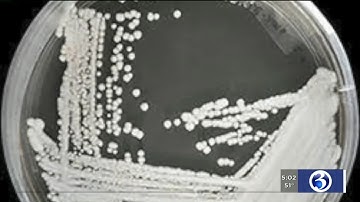
VIDEO: CDC warns about dangerous, multi-drug resistant
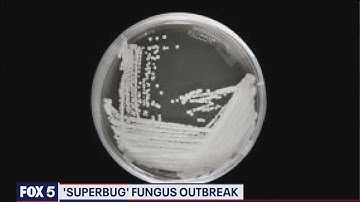
CDC: Evidence of untreatable

⬇ DOWNLOAD NOW
Kalau muncul iklan pop-up, tutup lalu klik tombol kembali
Download lagu Superbug Spread Prompts CDC Concern secara gratis hanya untuk keperluan promosi. Dukung artis favorit kamu dengan membeli musik original di iTunes atau platform resmi lainnya.
 CDC warns about spread of 'superbug'
CDC warns about spread of 'superbug'
 STARTING POINT: CDC Warns Of Potential Health Nightmare; Drug-Resistant Superbug Spreading
STARTING POINT: CDC Warns Of Potential Health Nightmare; Drug-Resistant Superbug Spreading
 GCTV - Revenge of the Superbugs: How Can We Outsmart Killer Microbes?
GCTV - Revenge of the Superbugs: How Can We Outsmart Killer Microbes?
 CDC warns about superbug
CDC warns about superbug
 Superbugs Moving From Hospitals to Homes
Superbugs Moving From Hospitals to Homes
CDC warns about drug-resistant superbug
CDC warns about drug-resistant superbug
VIDEO: CDC warns about dangerous, multi-drug resistant 'superbug'
VIDEO: CDC warns about dangerous, multi-drug resistant 'superbug'
CDC: Evidence of untreatable 'superbug' found at DC nursing home | FOX 5 DC
CDC: Evidence of untreatable 'superbug' found at DC nursing home | FOX 5 DC